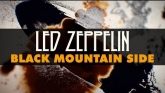
Embedded thumbnail

Товар успешно отложен. Вы можете продолжить выбор или просмотреть отложенные товары в корзине
- Главная
- /
- Led Zeppelin
- /
- Led Zeppelin
Расскажи своим друзьям
или копировать ссылку
Led Zeppelin / Led Zeppelin

Жанр:
Рок
Стиль:
Хард-рок
Формат:
Винил 12” (LP), 180 Gram Black Vinyl, Tri-fold
Носителей:
3
Состояние:
Новый
Происхождение:
Евросоюз
Штрих-код:
0081227964603
Кат. номер:
8122796460
Дата релиза:
26.08.2022
Производитель:
Warner Music
Товар в наличии на складе
5 105
Купить "Led Zeppelin (Лед Зепелинг) - Led Zeppelin" можно в следующих форматах:
Винил,
(
руб.)
Происхождение:
Импорт
Стоимость
5105
Винил,
(
руб.)
Происхождение:
Импорт
Стоимость
3345
Трек - лист
A1
Good Times Bad Times
A2
Babe I'm Gonna Leave You
A3
You Shook Me
A4
Dazed And Confused
B1
Your Time Is Gonna Come
B2
Black Mountain Side
B3
Communication Breakdown
B4
I Can't Quit You Baby
B5
How Many More Times
C1
Good Times, Bad Times / Communication Breakdown
C2
You Shook Me
C1
Heartbreaker
C2
Dazed And Confused
D1
White Summer / Black Mountain Side
D2
Moby Dick
E1
I Can't Quit You Baby
E2
How Many More Times
Ремастированное переиздание на тройном 180-граммовом виниле дебютного студийного альбома легендарной британской рок-группы Led Zeppelin, выпущенного Atlantic Records в январе 1969 года.

Жанр:
Рок
Стиль:
Хард-рок
Формат:
Винил 12” (LP), 180 Gram Black Vinyl
Носителей:
1
Состояние:
Новый
Происхождение:
Евросоюз
Штрих-код:
0081227966416
Кат. номер:
8122796641
Дата релиза:
29.07.2022
Производитель:
Warner Music
Лейбл:
Atlantic, Atlantic
Товар в наличии на складе
3 345
Купить "Led Zeppelin (Лед Зепелинг) - Led Zeppelin" можно в следующих форматах:
Винил,
(
руб.)
Происхождение:
Импорт
Стоимость
5105
Винил,
(
руб.)
Происхождение:
Импорт
Стоимость
3345
Трек - лист
A1
Good Times Bad Times
A2
Babe I'm Gonna Leave You
A3
You Shook Me
A4
Dazed And Confused
B1
Your Time Is Gonna Come
B2
Black Mountain Side
B3
Communication Breakdown
B4
I Can't Quit You Baby
B5
How Many More Times
Ремастированное переиздание на 180-граммовом виниле дебютного студийного альбома британской рок-группы Led Zeppelin, выпущенного на Atlantic Records в январе 1969 года.
Участники записи альбома
Bass, Organ, Backing Vocals – John Paul Jones
Design [Cover Design] – George Hardie
Drums, Timpani [Tympani], Backing Vocals – John Bonham
Electric Guitar, Acoustic Guitar, Pedal Steel Guitar, Backing Vocals – Jimmy Page
Engineer – Glyn Johns
Executive-Producer – Peter Grant
Lacquer Cut By – John Davis (4)
Lead Vocals, Harmonica – Robert Plant
Photography By [Back Liner Photo] – Chris Dreja
Producer – Jimmy Page
Remastered By – Jimmy Page

Led Zeppelin - Good Times Bad Times (Official Audio)

Led Zeppelin – Good Times Bad Times

Led Zeppelin - Babe I'm Gonna Leave You (Official Audio)

Led Zeppelin – Communication Breakdown

Led Zeppelin - You Shook Me (Official Audio)

Led Zeppelin - Dazed And Confused (Official Audio)

Led Zeppelin - Your Time Is Gonna Come (Official Audio)
Led Zeppelin - Black Mountain Side (Official Audio)

Led Zeppelin - Communication Breakdown (Official Audio)

Led Zeppelin - I Can't Quit You Baby (Official Audio)

Led Zeppelin - How Many More Times (Official Audio)
Вам могут также понравиться
25